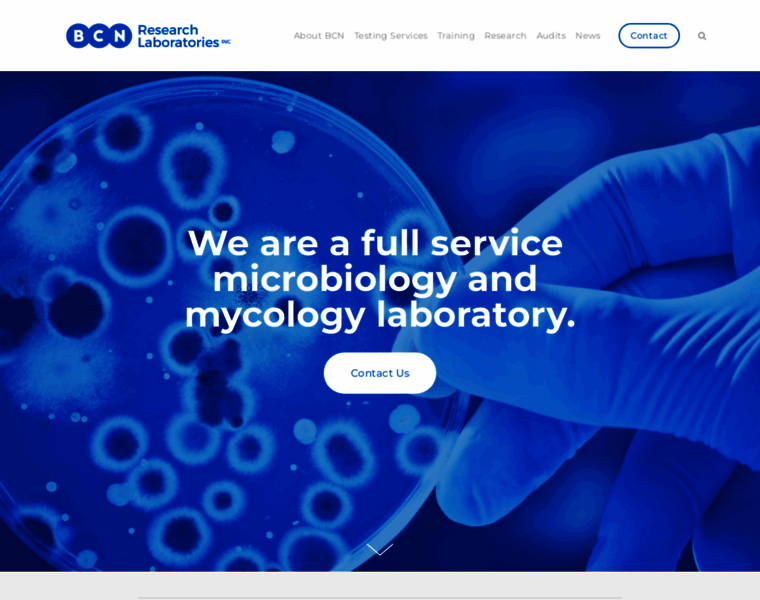

Bcnlabs.com
Visit bcnlabs.com-
2 months ago
Last scanned
-
25 years
Domain Age
-
No data
Daily Visitors
-
No data
Global Rank
Bcnlabs.com
Visit bcnlabs.com
About Website
Updated:
BCN Research Laboratories
BCN is a full service microbiology laboratory. It offers an extensive selection of microbiological and mycological tests (yeast and mold testing), training and auditing programs. It specializes in food and beverage spoilage and pathogen contamination assessment and prevention with a strong background in heat-resistant molds (HRM), Alicyclobacillus (ACB) and preservative resistant yeast.

Network Data
This website is hosted with Squarespace, Inc., which reserves the following IP addresses for bcnlabs.com: 198.49.23.144, 198.49.23.145, 198.185.159.144, 198.185.159.145. Moreover, DNS used with this website include dns1.p07.nsone.net, dns2.p07.nsone.net, dns3.p07.nsone.net, dns4.p07.nsone.net, ns01.squarespacedns.com, ns02.squarespacedns.com, ns03.squarespacedns.com, ns04.squarespacedns.com. Subnet identifier ranges from 198.185.159.0 to 198.185.159.255. Classless Inter-Domain Routing (CIDR) is 198.185.159.0/24. ARIN net type is Direct Allocation.
-
2 months ago
Last scanned
-
25 years
Domain Age
-
No data
Daily Visitors
-
No data
Global Rank
Network
ADDRESSING DETAILS
-
Hosting Company
-
IPs
198.49.23.144, 198.49.23.145, 198.185.159.144, 198.185.159.145
-
DNS
dns1.p07.nsone.net
dns2.p07.nsone.net
dns3.p07.nsone.net
dns4.p07.nsone.net
ns01.squarespacedns.com
ns02.squarespacedns.com
ns03.squarespacedns.com
ns04.squarespacedns.com
Whois
OWNERSHIP
-
Created
2000-09-29
-
Expires
2026-09-29
-
Owner
-
Registar
TUCOWS DOMAINS INC.
-
Owner Emails
Domain & Keywords
The registrar of bcnlabs.com is TUCOWS DOMAINS INC. and the name expires on 2026-09-29. Owner email is obscured for security reasons, so you cannot reach them directly. Their country of residence is Canada.
- confectioneries
- capri sun mold
- sweeters
- mold for kids
- aciduric bacteria
Websites similar to bcnlabs.com
-
 door251.com
door251.com-
Global rank
N/A
-
Daily Visitors
N/A
-
-
 littleredfish.com
littleredfish.com-
Global rank
N/A
-
Daily Visitors
N/A
-
-
 sunpoplife.com
sunpoplife.com-
Global rank
N/A
-
Daily Visitors
534
-
-
 eventfun.co.nz
eventfun.co.nz-
Global rank
N/A
-
Daily Visitors
N/A
-
-
 worlds-forum.com
worlds-forum.com-
Global rank
N/A
-
Daily Visitors
N/A
-
